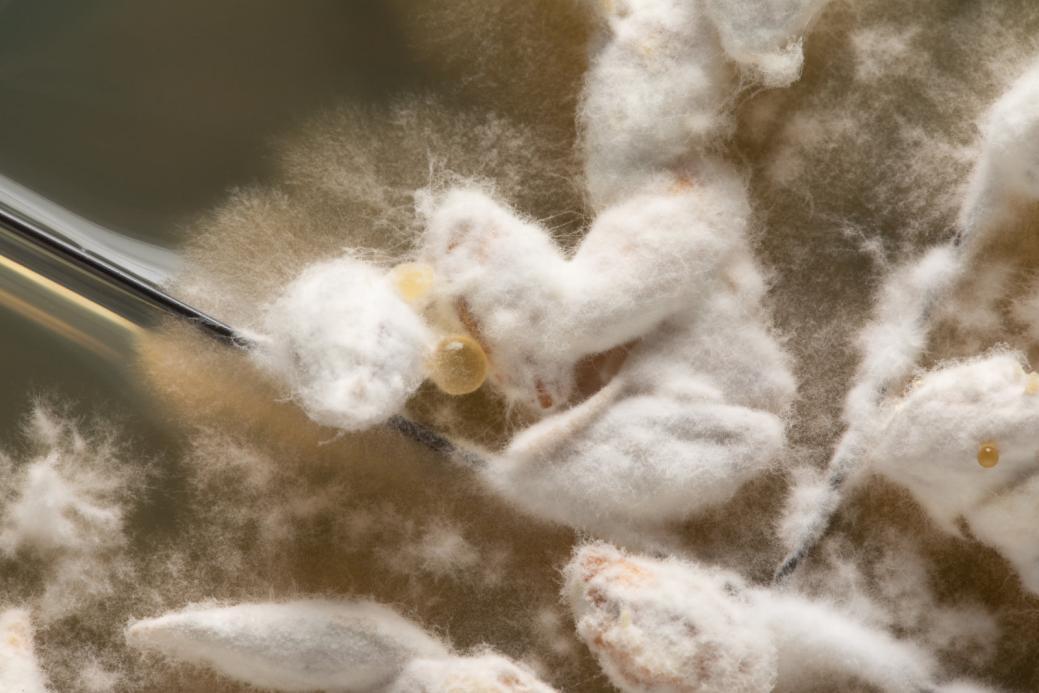

出品:科普中国
作者:Denovo团队
监制:中国科普博览
生物制造,这个名词听起来也许让你首先联想到生物制药或高级生物燃料。然而,该领域的应用已经远远超出了这些范畴。从乙醇到可降解塑料(如聚乳酸),生物制造正在悄无声息地改变我们的日常生活。最近,这一技术还涉足了一个看似不太可能的领域:房屋建造。
目前,生物制造在建筑领域的主要应用包括但不限于“自修复混凝土”“生物水泥”以及“菌丝材料”。这些创新性的应用不仅展示了生物制造在建筑工程中的巨大潜力,也为我们打开了一个全新的研究和应用维度。

在建筑中铺设水泥
(图片来源:veer图库)
芽孢杆菌用于修复墙面裂缝
混凝土是由水泥、沙石和水按照特定比例混合而成的建筑材料,以其低成本、高抗压强度和出色的耐久性而被广泛应用于土木工程项目之中。
尽管混凝土在理想环境下具有与天然石材相匹敌的长寿命,但由于长期受到风吹、日晒、雨淋以及冬夏季节交替导致的冻融循环影响,其实际寿命往往大打折扣。这不仅增加了房屋、桥梁和隧道的维护频率,而且会提高维修成本。

房屋裂缝
(图片来源:作者拍摄)
为了解决这一耐久性问题,科学家们开发了具有自我修复能力的混凝土。荷兰微生物学家Hendrik Jonkers受到人体骨细胞通过钙化自我修复的机制启发,研发出了一种名为“生物混凝土”(Bio-concrete)的材料,其突出特点便是具备自我修复能力。生物混凝土中含有一种名为芽孢杆菌的微生物,这种微生物能在石灰环境中生存,并能在缺乏食物和氧气的条件下以孢子形式存活近两百年。
当这种芽孢杆菌与乳酸钙混合用于生产混凝土时,一旦混凝土出现裂缝,渗透进来的雨水会唤醒休眠的孢子。这些复苏的孢子开始消耗乳酸钙,并释放钙离子,与水中的碳酸根离子反应生成碳酸钙(石灰石),从而自动修复裂缝。
完成修复后,由于雨水不再渗透进来,生长环境被破坏,孢子将重新进入休眠状态,待机应对未来的损伤。研究显示,这种生物混凝土能在约三周内自行修复宽度约0.5毫米的裂缝,极大地延长了建筑物的使用寿命。
这种自修复混凝土不仅能节省昂贵的维护成本,还能提高建筑物的安全性。然而,由于当前这一技术的成本相对较高,它尚未在大规模建设项目中得到广泛应用。

芽孢杆菌与自修复混凝土
(图片来源:参考文献[1])
添加硅藻的“生物水泥”
上面谈到的混凝土,其主要成分是水泥,水泥在全球范围内的生产和使用量都相当庞大。然而,这一行业也是全球二氧化碳排放的主要“贡献”者。在这一背景下,生物制造技术为水泥产业带来了创新性的解决方案。
硅藻是一种单细胞自养微生物,以其在水体中的快速繁殖而闻名。硅藻的细胞壁含有多孔结构的二氧化硅,这一物质能有效增强材料的机械强度。
通过将硅藻纳入水泥制造过程,形成所谓的“生物水泥”,能够提升水泥的力学性能和流变特性,进而减少所需的水泥量。这不仅有助于降低碳排放,还能增加碳的生物捕获能力。然而,这一技术目前同样面临着成本效益等方面的挑战。

硅藻
(图片来源:维基百科)
除此之外,硅藻还有其他应用价值。例如在制造硅藻泥方面,硅藻泥由经历了亿万年演化的硅藻和其他浮游生物的沉积物构成,是一种新型环保材料。该材料可以用于替代乳胶漆和壁纸,作为别墅、酒店、公寓和医院等场所墙面装饰的理想选择。
硅藻泥不仅肌理丰富、色彩柔和,而且具有极强的物理吸附能力,能有效吸附室内空气中的有害物质,如游离甲醛、苯、氨等,以及消除由吸烟和垃圾产生的异味,从而净化室内空气。
蘑菇的菌丝也能盖楼?
尽管蘑菇通常被视为一种“蔬菜”,但它其实并不属于植物,而是一种真菌微生物。
更值得注意的是,我们日常食用的只是蘑菇的子实体部分。实际上,蘑菇下方(或在腐烂的木头内部)存在着由无数细胞组成的菌丝网络,也称为菌丝体。
菌丝体
(图片来源:veer图库)
这些菌丝是真菌用于吸收、传输和储存营养的主要结构单位,它们的细胞壁主要由几丁质、葡聚糖和蛋白质组成。
几丁质的抗拉伸强度与碳纤维相当,而且具有优异的热稳定性和阻燃性。这些特点使得菌丝成为材料科学家关注的焦点,并开始被用于建筑材料的开发和制造。
在纽约就有一座名为“Hy-Fi”的临时室外生物降解展馆。这座展馆是由菌丝体砖块搭建而成的,这些砖块仅需5天的时间即可完成生长。之后,这些砖块被堆叠成三个交织的圆柱体结构,其独特的造型非常引人注目。

菌丝材料用于建造室外展馆
(图片来源:参考文献[6])
结语
生物制造技术为建筑行业带来了颠覆性的创新,从延长建筑物使用寿命的“自修复混凝土”,到减少碳排放的“生物水泥”,再到快速、高效的“菌丝材料”。相信在不远的未来,这些生物制造技术将被更广泛地应用于房屋建造,为我们的居住环境增添更多可能性和乐趣。
参考文献:
[1]Henk M. Jonkers. Self healing concrete: a biological approach. Springer Series in Materials Science, 2007, 100, 195-204.
[2]于漧,包亚芳. 硅藻土作高性能混凝土掺合料的改性效果. 建筑石膏与胶凝材料, 2003, 12, 11-12.
[3]郭彬达, 方聪聪. 解析环保装饰材料硅藻泥. 江西建材, 2017(19):286-286.
[4]王静, 冀志江, 张琎珺等. 硅藻泥装饰壁材研发、评价及应用技术. 建筑科技, 2018, 366, 30-33.
[5]Ekaraj Paudel, Remko M. Boom, Els van Haaren, et al. Effects of cellular structure and cell wall components on water holding capacity of mushrooms. Journal of Food Engineering, 2016, 187: 106-113.
[6]Avinash Rajagopal. Behind the living’s "100% Organic" pavilion for MoMA PS1Metropolis, 2014-2-10.
欢迎扫码关注深i科普!
我们将定期推出
公益、免费、优惠的科普活动和科普好物!



- 参加最新科普活动
- 认识科普小朋友
- 成为科学小记者
 会员登录
会员登录






























